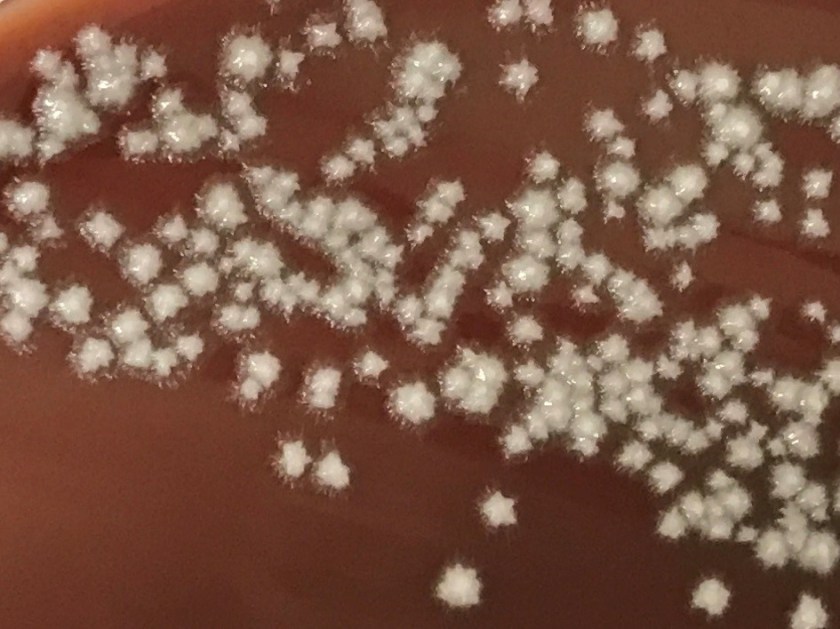
candalbi2

Case Histor
A 50 year old man presented to the emergency room with altered mental status, fever, and hypotension. His medical history was significant for quadriplegia, chronic indwelling urinary catheter with frequent urinary tract infections, and diabetes mellitus. The patient was intubated and started on vasopressors for presumed septic shock. CT scan of the abdomen showed dilated loops of bowel with possible ileus and pneumoperitoneum around the sigmoid colon.
Laboratory Identification
- Clostridium difficile Fecal PCR: Negative
- Fecal Bacterial Pathogen PCR: Negative for Salmonella spp., Shigella or Enteroinvasive E. coli spp., Campylobacter spp., or Shiga toxin producing genes
- Urine culture: 2 strains of Pseudomonas aeruginosa and Klebsiella pneumoniae
Blood culture: At 41 hours, two of four blood culture bottles became positive (one aerobic bottle in each set). Gram stain showed budding yeast with pseudohyphae (Image 1). Growth of white, smooth colonies with foot-like projections was observed on agar (Image 2). MALDI-TOF analysis confirmed identification of the organism as Candida albicans.

Discussion
Candida spp. are the most common yeast cultured from clinical specimens. Candida albicans is characterized macroscopically by growth of smooth, white colonies with surrounding “feet” which represent projections of pseudohyphae. The pseudohyphae are distinguished microscopically from true hyphae by constriction of the cells where they meet (with true hyphae, the cell walls will remain parallel). When incubated at 37 C for 2 hours C. albicans will produce germ tubes (extensions from the yeast cell representing an attempt at forming true hyphae).
Candida spp. are normal flora found in the gastrointestinal tract, mucous membranes, and skin. Invasive candidiasis is typically an opportunistic infection with the patient’s own, endogenous flora (although nosocomial spread also occurs). Although it can be normal skin flora, the growth of Candida spp. from a blood culture should be presumed to be pathogenic; treatment should be initiated, and attempts made to identify the source. Typically, invasive candidiasis arises from one of three sources: 1) colonization and biofilm formation on an indwelling intravenous catheter 2) dissemination from a deep nidus of infection (often urinary tract) or 3) translocation from the gastrointestinal tract. Patients in intensive care, those who are immunocompromised, at extremes of age, those who have been on broad spectrum antibiotics, and those with GI tract perforation or anastamotic leaks post-operatively are at greatest risk for developing invasive candidiasis.
C. albicans has historically been the most common species of yeast causing invasive disease. However, non-albicans species (C. glabrata, C. parapsilosis, C. tropicalis and C. krusei) now cause almost 50% of invasive candidiasis. This changing epidemiology is relevant because the different species demonstrate different susceptibility profiles to antifungal agents, including azoles and echinocandins. C. auris is another recently emerging species that shows resistance to multiple antifungal agents, and has been described as causing outbreaks of healthcare-associated infections.
Although the patient’s chronic indwelling urinary catheter raised suspicion for a urinary source of the candidemia, the urine culture failed to support that theory. Given the findings of the CT abdomen in this patient, translocation from the GI tract is favored as the source of the candidemia. The patient’s history of treatment with antibiotics for repeated urinary tract infections, however, may have placed him at greater risk for developing invasive candidiasis.
-Alison Krywanczyk, MD is a 4th year anatomic and clinical pathology resident at the University of Vermont Medical Center.

-Christi Wojewoda, MD, is the Director of Clinical Microbiology at the University of Vermont Medical Center and an Associate Professor at the University of Vermont.